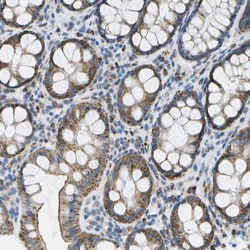
Invitrogen PTGIS Polyclonal Antibody 100 &mu;L; Unconjugated:Antibodies,

missing translation for 'onlineSavingsMsg'
Learn More
Learn More
Invitrogen™ PTGIS Polyclonal Antibody


Rabbit Polyclonal Antibody
Brand: Invitrogen™ PA553132
This item is not returnable.
View return policy
Description
Immunogen sequence: LTLYGIEALP RTHESQAQDR VHSADVFHTF RQLDRLLPKL ARGSLSVGDK DHMCSVKSRL WKLLSPARLA RRAHRSKWLE SYLLHLEEMG VSEEMQARAL VLQLWATQGN MGPAAFWLLL FLLKNPEALA AVRGELESIL WQAEQ Highest antigen sequence identity to the following orthologs: Mouse - 89%, Rat - 85%.
CYP8A1 is a member of the cytochrome P450 superfamily of enzymes. The cytochrome P450 proteins are monooxygenases which catalyze many reactions involved in drug metabolism and synthesis of cholesterol, steroids and other lipids. However, this protein is considered a member of the cytochrome P450 superfamily on the basis of sequence similarity rather than functional similarity. This endoplasmic reticulum membrane protein catalyzes the conversion of prostglandin H2 to prostacyclin (prostaglandin I2), a potent vasodilator and inhibitor of platelet aggregation. An imbalance of prostacyclin and its physiological antagonist thromboxane A2 contribute to the development of myocardial infarction, stroke, and atherosclerosis.
Specifications
| PTGIS | |
| Polyclonal | |
| Unconjugated | |
| PTGIS | |
| Cyp8; CYP8A1; cytochrome P450 8A1; cytochrome P450, family 8, subfamily A, polypeptide 1; hydroperoxy icosatetraenoate dehydratase; LOW QUALITY PROTEIN: prostacyclin synthase; MGC126858; MGC126860; PGIS; Prostacyclin synthase; prostaglandin I2 (prostacyclin) synthase; prostaglandin I2 (prostacyclin) synthase like; prostaglandin I2 synthase; PTGI; ptgis; ptgisl | |
| Rabbit | |
| Antigen affinity chromatography | |
| RUO | |
| 5740 | |
| Store at 4°C short term. For long term storage, store at -20°C, avoiding freeze/thaw cycles. | |
| Liquid |
| Immunohistochemistry (Paraffin), Western Blot | |
| 0.1 mg/mL | |
| PBS with 40% glycerol and 0.02% sodium azide; pH 7.2 | |
| Q16647 | |
| PTGIS | |
| Recombinant protein corresponding to Human PTGIS. Recombinant protein control fragment (Product #RP-90174). | |
| 100 μL | |
| Primary | |
| Human | |
| Antibody | |
| IgG |
Product Content Correction
Your input is important to us. Please complete this form to provide feedback related to the content on this product.
Product Title
Spot an opportunity for improvement?Share a Content Correction